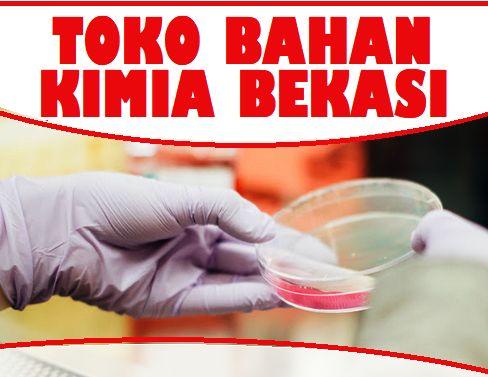
Toko Jual Bahan Kimia di Bekasi

Daftar Distributor + Toko Bahan Kimia Jakarta Barat – Daftar Alamat Telepon

Apa itu Toko Bahan Kimia Jakarta Barat?
Toko Bahan Kimia Jakarta Barat adalah sebuah toko yang menyediakan berbagai macam bahan kimia yang dibutuhkan untuk keperluan industri, penelitian, dan laboratorium. Toko ini menyediakan berbagai jenis bahan kimia dengan kualitas terjamin dan harga yang kompetitif.
Mengapa Memilih Toko Bahan Kimia Jakarta Barat?
Ada beberapa alasan mengapa Anda harus memilih Toko Bahan Kimia Jakarta Barat untuk memenuhi kebutuhan bahan kimia Anda.
Pertama, toko ini menawarkan produk bahan kimia yang berkualitas tinggi. Semua bahan kimia yang dijual di toko ini telah melewati proses pengujian yang ketat untuk memastikan kualitasnya. Dengan demikian, Anda dapat yakin bahwa Anda akan mendapatkan bahan kimia yang aman dan efektif.
Kedua, toko ini memiliki berbagai macam jenis bahan kimia. Dengan begitu, Anda dapat dengan mudah menemukan bahan kimia yang sesuai dengan kebutuhan Anda. Baik itu untuk keperluan industri, penelitian, atau laboratorium, toko ini akan menyediakan semua yang Anda butuhkan.
Selain itu, toko ini juga menawarkan layanan pengiriman. Jadi, Anda tidak perlu repot-repot datang ke toko fisik untuk membeli bahan kimia. Anda dapat dengan mudah memesan bahan kimia yang Anda butuhkan melalui telepon atau online, dan toko ini akan mengirimkannya langsung ke tempat Anda.
Cara Mendapatkan Bahan Kimia di Toko Bahan Kimia Jakarta Barat
Untuk mendapatkan bahan kimia di Toko Bahan Kimia Jakarta Barat, Anda dapat mengikuti langkah-langkah berikut:
- Menentukan jenis bahan kimia yang Anda butuhkan. Pastikan Anda telah mengetahui dengan jelas bahan kimia apa yang Anda perlukan, termasuk spesifikasinya.
- Menghubungi toko melalui nomor telepon yang tertera untuk melakukan pemesanan. Anda dapat memberikan informasi mengenai jenis bahan kimia yang Anda butuhkan dan jumlah yang diinginkan.
- Menyepakati metode pembayaran. Setelah Anda melakukan pemesanan, Anda perlu menyepakati metode pembayaran yang akan digunakan. Toko ini biasanya menerima pembayaran melalui transfer bank atau tunai.
- Menunggu proses pengiriman. Setelah Anda melakukan pembayaran, toko ini akan segera mengirimkan bahan kimia yang Anda pesan. Anda dapat menunggu bahan kimia tiba di tempat Anda.
Biaya Bahan Kimia di Toko Bahan Kimia Jakarta Barat
Biaya bahan kimia di Toko Bahan Kimia Jakarta Barat bervariasi tergantung pada jenis bahan kimia yang Anda beli dan jumlahnya. Harga bahan kimia juga dapat dipengaruhi oleh faktor lain seperti kualitas, merek, dan permintaan pasar.
Jurusan atau Profesi yang Membutuhkan Bahan Kimia
Bahan kimia digunakan dalam berbagai bidang, dan ada beberapa jurusan atau profesi yang membutuhkan bahan kimia secara rutin. Beberapa di antaranya meliputi:
- Industri farmasi: Jurusan farmasi dan industri farmasi membutuhkan bahan kimia untuk produksi obat-obatan dan produk farmasi lainnya.
- Penelitian dan pengembangan: Jurusan ilmu pengetahuan, seperti kimia, biologi, dan fisika, memerlukan bahan kimia untuk melakukan penelitian dan eksperimen.
- Industri kosmetik: Jurusan kosmetik dan industri kosmetik menggunakan bahan kimia untuk membuat produk kecantikan seperti perawatan kulit, rambut, dan makeup.
- Industri makanan dan minuman: Jurusan makanan dan minuman membutuhkan bahan kimia untuk proses produksi makanan dan minuman, seperti pewarna, pengawet, dan perasa buatan.
Jadi, jika Anda memilih salah satu jurusan atau profesi ini, kemungkinan besar Anda akan membutuhkan bahan kimia dalam pekerjaan Anda.
Toko Bahan Kimia Di Bekasi Utara – Sekilas Bahan

Apa itu Toko Bahan Kimia Bekasi Utara?
Toko Bahan Kimia Bekasi Utara adalah salah satu toko yang menyediakan berbagai bahan kimia yang diperlukan untuk keperluan industri, penelitian, dan laboratorium. Toko ini berlokasi di Bekasi Utara dan menawarkan berbagai macam jenis bahan kimia dengan kualitas terjamin dan harga yang kompetitif.
Mengapa Memilih Toko Bahan Kimia Bekasi Utara?
Ada beberapa alasan mengapa Anda harus memilih Toko Bahan Kimia Bekasi Utara untuk memenuhi kebutuhan bahan kimia Anda.
Pertama, toko ini menyediakan produk bahan kimia yang berkualitas tinggi. Semua bahan kimia yang dijual di toko ini telah melewati proses pengujian yang ketat untuk memastikan kualitasnya. Dengan demikian, Anda dapat yakin bahwa Anda akan mendapatkan bahan kimia yang aman dan efektif.
Kedua, toko ini memiliki berbagai macam jenis bahan kimia. Dengan begitu, Anda dapat dengan mudah menemukan bahan kimia yang sesuai dengan kebutuhan Anda. Baik itu untuk keperluan industri, penelitian, atau laboratorium, toko ini akan menyediakan semua yang Anda butuhkan.
Selain itu, toko ini juga menawarkan harga yang kompetitif. Dengan begitu, Anda dapat mendapatkan bahan kimia berkualitas tinggi dengan harga yang terjangkau.
Cara Mendapatkan Bahan Kimia di Toko Bahan Kimia Bekasi Utara
Untuk mendapatkan bahan kimia di Toko Bahan Kimia Bekasi Utara, Anda dapat mengikuti langkah-langkah berikut:
- Menentukan jenis bahan kimia yang Anda butuhkan. Pastikan Anda telah mengetahui dengan jelas bahan kimia apa yang Anda perlukan, termasuk spesifikasinya.
- Menghubungi toko melalui nomor telepon yang tertera untuk melakukan pemesanan. Anda dapat memberikan informasi mengenai jenis bahan kimia yang Anda butuhkan dan jumlah yang diinginkan.
- Menyepakati metode pembayaran. Setelah Anda melakukan pemesanan, Anda perlu menyepakati metode pembayaran yang akan digunakan. Toko ini biasanya menerima pembayaran melalui transfer bank atau tunai.
- Menunggu proses pengiriman. Setelah Anda melakukan pembayaran, toko ini akan segera mengirimkan bahan kimia yang Anda pesan. Anda dapat menunggu bahan kimia tiba di tempat Anda.
Biaya Bahan Kimia di Toko Bahan Kimia Bekasi Utara
Biaya bahan kimia di Toko Bahan Kimia Bekasi Utara bervariasi tergantung pada jenis bahan kimia yang Anda beli dan jumlahnya. Harga bahan kimia juga dapat dipengaruhi oleh faktor lain seperti kualitas, merek, dan permintaan pasar.
Jurusan atau Profesi yang Membutuhkan Bahan Kimia
Bahan kimia digunakan dalam berbagai bidang, dan ada beberapa jurusan atau profesi yang membutuhkan bahan kimia secara rutin. Beberapa di antaranya meliputi:
- Industri farmasi: Jurusan farmasi dan industri farmasi membutuhkan bahan kimia untuk produksi obat-obatan dan produk farmasi lainnya.
- Penelitian dan pengembangan: Jurusan ilmu pengetahuan, seperti kimia, biologi, dan fisika, memerlukan bahan kimia untuk melakukan penelitian dan eksperimen.
- Industri kosmetik: Jurusan kosmetik dan industri kosmetik menggunakan bahan kimia untuk membuat produk kecantikan seperti perawatan kulit, rambut, dan makeup.
- Industri makanan dan minuman: Jurusan makanan dan minuman membutuhkan bahan kimia untuk proses produksi makanan dan minuman, seperti pewarna, pengawet, dan perasa buatan.
Jadi, jika Anda memilih salah satu jurusan atau profesi ini, kemungkinan besar Anda akan membutuhkan bahan kimia dalam pekerjaan Anda.
Alamat Toko Jual Bahan Kimia di Bekasi – Daftar Alamat Telepon Indonesia
Apa itu Toko Jual Bahan Kimia di Bekasi?
Toko Jual Bahan Kimia di Bekasi adalah sebuah toko yang menyediakan berbagai macam bahan kimia yang dibutuhkan untuk keperluan industri, penelitian, dan laboratorium. Toko ini merupakan salah satu pilihan terbaik jika Anda sedang mencari bahan kimia dengan kualitas terbaik dan harga yang kompetitif di kota Bekasi.
Mengapa Memilih Toko Jual Bahan Kimia di Bekasi?
Ada beberapa alasan mengapa Anda harus memilih Toko Jual Bahan Kimia di Bekasi untuk memenuhi kebutuhan bahan kimia Anda.
Pertama, toko ini menawarkan berbagai macam jenis bahan kimia. Dengan begitu, Anda dapat dengan mudah menemukan bahan kimia yang sesuai dengan kebutuhan Anda. Baik itu untuk keperluan industri, penelitian, atau laboratorium, toko ini akan menyediakan semua yang Anda butuhkan.
Kedua, toko ini menyediakan bahan kimia dengan kualitas terbaik. Semua bahan kimia yang dijual di toko ini telah melewati proses pengujian yang ketat untuk memastikan kualitasnya. Dengan demikian, Anda dapat yakin bahwa Anda akan mendapatkan bahan kimia yang aman dan efektif.
Selain itu, toko ini juga menawarkan harga yang kompetitif. Dengan begitu, Anda dapat mendapatkan bahan kimia berkualitas tinggi dengan harga yang terjangkau.
Cara Mendapatkan Bahan Kimia di Toko Jual Bahan Kimia di Bekasi
Untuk mendapatkan bahan kimia di Toko Jual Bahan Kimia di Bekasi, Anda dapat mengikuti langkah-langkah berikut:
- Menentukan jenis bahan kimia yang Anda butuhkan. Pastikan Anda telah mengetahui dengan jelas bahan kimia apa yang Anda perlukan, termasuk spesifikasinya.
- Menghubungi toko melalui nomor telepon yang tertera untuk melakukan pemesanan. Anda dapat memberikan informasi mengenai jenis bahan kimia yang Anda butuhkan dan jumlah yang diinginkan.
- Menyepakati metode pembayaran. Setelah Anda melakukan pemesanan, Anda perlu menyepakati metode pembayaran yang akan digunakan. Toko ini biasanya menerima pembayaran melalui transfer bank atau tunai.
- Menunggu proses pengiriman. Setelah Anda melakukan pembayaran, toko ini akan segera mengirimkan bahan kimia yang Anda pesan. Anda dapat menunggu bahan kimia tiba di tempat Anda.
Biaya Bahan Kimia di Toko Jual Bahan Kimia di Bekasi
Biaya bahan kimia di Toko Jual Bahan Kimia di Bekasi bervariasi tergantung pada jenis bahan kimia yang Anda beli dan jumlahnya. Harga bahan kimia juga dapat dipengaruhi oleh faktor lain seperti kualitas, merek, dan permintaan pasar.
Jurusan atau Profesi yang Membutuhkan Bahan Kimia
Bahan kimia digunakan dalam berbagai bidang, dan ada beberapa jurusan atau profesi yang membutuhkan bahan kimia secara rutin. Beberapa di antaranya meliputi:
- Industri farmasi: Jurusan farmasi dan industri farmasi membutuhkan bahan kimia untuk produksi obat-obatan dan produk farmasi lainnya.
- Penelitian dan pengembangan: Jurusan ilmu pengetahuan, seperti kimia, biologi, dan fisika, memerlukan bahan kimia untuk melakukan penelitian dan eksperimen.
- Industri kosmetik: Jurusan kosmetik dan industri kosmetik menggunakan bahan kimia untuk membuat produk kecantikan seperti perawatan kulit, rambut, dan makeup.
- Industri makanan dan minuman: Jurusan makanan dan minuman membutuhkan bahan kimia untuk proses produksi makanan dan minuman, seperti pewarna, pengawet, dan perasa buatan.
Jadi, jika Anda memilih salah satu jurusan atau profesi ini, kemungkinan besar Anda akan membutuhkan bahan kimia dalam pekerjaan Anda.
7 Rekomendasi Toko Bahan Kimia di Bandung Terlengkap dan Terdekat

Apa itu Toko Bahan Kimia di Bandung?
Toko Bahan Kimia di Bandung adalah sebuah toko yang menyediakan berbagai macam bahan kimia yang dibutuhkan untuk keperluan industri, penelitian, dan laboratorium. Toko ini berlokasi di kota Bandung dan menawarkan berbagai jenis bahan kimia dengan kualitas terjamin dan harga yang terjangkau.
Mengapa Memilih Toko Bahan Kimia di


